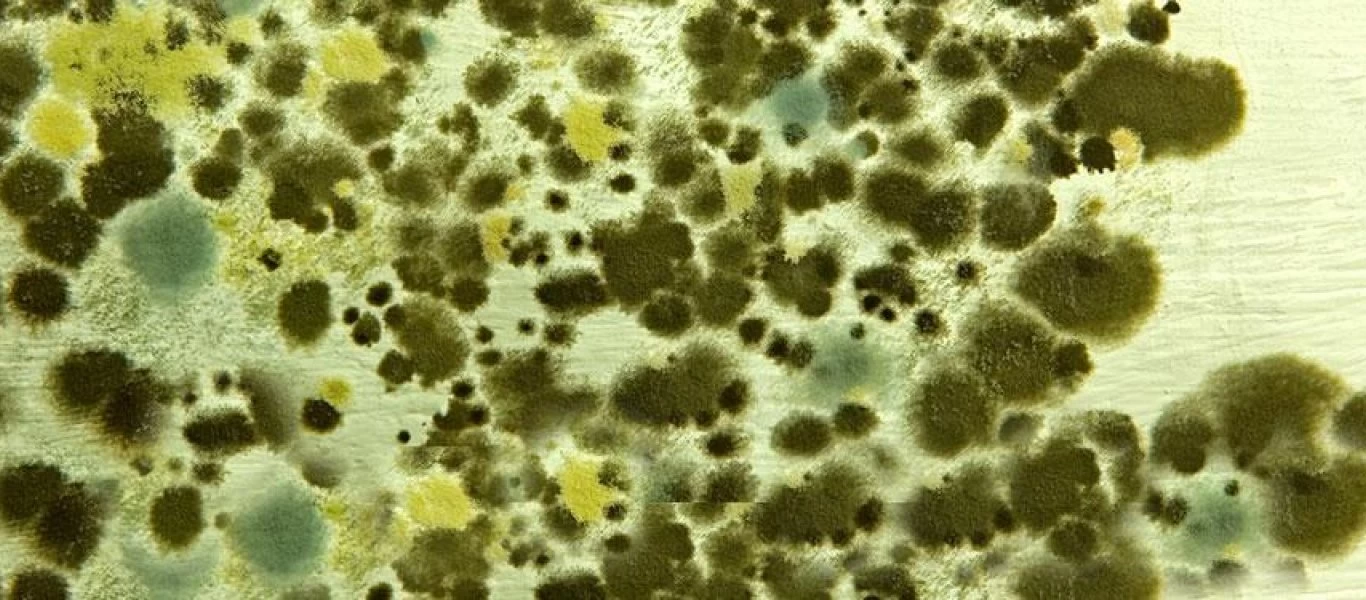
Mυρίζει το σπίτι υγρασία; - Με αυτό το κόλπο θα αλλάξει μυρωδιά

Lifestyle
-

GNTM spoiler μεγατόνων: Η κουκλάρα παίκτρια που διώχνουν πρώτη απ’ το παιχνίδι λόγω… συμπεριφοράς
Δυστυχώς στα παιχνίδια ομορφιάς δεν συνεχίζουν πάντα οι ομορφότερες αλλά οι «καταλληλότερες».Tην έχουμε ήδη δει να παίρνει το εισιτήριο για το bootcamp, όλοι παραδεχτήκαμε πως η ομορφιά της είναι απίσ...
Read More » -

Γιατί κάποιοι άνθρωποι αργούν πάντα στα ραντεβού τους;
Η συνέπεια είναι μια αρετή, που δυστυχώς δε διαθέτουν όλοι. Παρά το γεγονός, ότι η αργοπορία θεωρείται γυναικείο χαρακτηριστικό, αυτό αποτελεί περισσότερο «αστικό μύθο», παρά αλήθεια. Γιατί αργούν όμω...
Read More » -

Η Trista Mikail κυνηγά το όνειρό της στο Los Angeles (φωτο)
H Trista Mikail, για όσους δεν γνωρίζουν, είναι ένα από τα αγαπημένα μοντέλο του γνωστού αντρικου περιοδικού Maxim. Η Trista, γεννημένη στο Idaho των H.Π.Α μετακόμισε σε νεαρή ηλικία στο Los Angeles γ...
Read More » -

Έρχεται η τηλεοπτική σειρά – υπερπαραγωγή «Άρχοντας των Δαχτυλιδιών»
Η αμερικανική κολοσσιαία εταιρεία Amazon ανακοίνωσε σήμερα ότι μέσα σε μερικούς μήνες θα ξεκινήσουν γυρίσματα στη Νέα Ζηλανδία για την τηλεοπτική μεταφορά της μεγάλης κινηματογραφικής επιτυχίας «Ο Άρχ...
Read More » -
Mυρίζει το σπίτι υγρασία; - Με αυτό το κόλπο θα αλλάξει μυρωδιά
Όσο και αν σου φανεί παράδοξο, σύμμαχος στη μάχη σου για τις δυσάρεστες μυρωδιές της υγρασίας είναι το μάλλον εξίσου δύσοσμο… κρεμμύδι.Κόψε ένα κρεμμύδι στη μέση και αφού το βάλεις σε ένα πιάτο, άφησέ...
Read More » -

GNTM 2: Η παίκτρια που εκνεύρισε τον Άγγελο Μπράτη - «Το μαλλί σου είναι σαν περούκα» (βίντεο)
Τον εκνευρισμό του Άγγελου Μπράτη προκάλεσε το styling στα μαλλιά διαγωνιζόμενης στο GNTM, με αποτέλεσμα να της δείξει με έντονο τρόπο την πόρτα της εξόδου από το παιχνίδι.Πιο συγκεκριμένα, η Μαρία εμ...
Read More » -

Η Bella Hadid φόρεσε το πιο διάφανο μπλουζάκι της και βγήκε στους δρόμους του Λονδίνου (φωτο)
Aφού περπάτησε στο σόου της Burberry στο Λονδίνο, η Bella Hadid εμφανίστηκε στους δρόμους της πόλης με ένα σχετικά casual λουκ το οποίο περιελάμβανε ένα μπεζ τζάκετ διακοσμημένο με μια μικροσκοπική κα...
Read More » -

GNTM 2: Η κτηνοτρόφος από τα Γιαννιτσά δεν άρεσε τελικά στους κριτές (βίντεο)
Tην πόρτα του GNTM 2 χτύπησε και μια κτηνοτρόφος.Ο λόγος για την 26χρονη Χριστίνα από τα Γιαννιτσά, η οποία κατά δήλωσή της ασχολείται με την κτηνοτροφία και τα χωράφια, ενώ είναι συμπαρουσιάστρια και...
Read More » -

Ηχηρό «χαστούκι» Φ. Σκορδά σε Γ. Λιάγκα!
Από χθες Δευτέρα ξεκίνησε ο πλήρης ανταγωνισμός στα τηλεοπτικά κανάλια, έχοντας το καθένα σχεδιάσει τη στρατηγική του για αυτήν τη σεζόν. Μεγάλο ενδιαφέρον έχει φυσικά ο ανταγωνισμός στην πρωινή ζώνη...
Read More » -

Έρευνα δείχνει ποια είναι η χειρότερη μέρα να απολυθεί κάποιος από τη δουλειά του
Η απόλυση είναι ένα από τα πιο αγχωτικά πράγματα που μπορεί να συμβεί σε έναν άνθρωπο. Aποτελεί μια συναισθηματικά φορτισμένη διαδικασία, την οποία βιώνουν σχεδόν όλοι και μπορεί να προκαλέσει πολλά α...
Read More »
